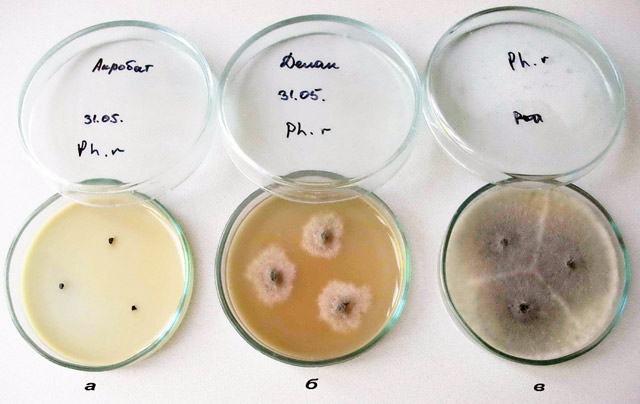
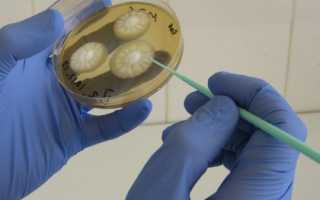

Как сдавать бак посев мочи в детском возрасте? Чтобы получить максимально точные результаты, следует правильно собрать мочу. Для анализа подходит лишь утренняя урина, в то время как у новорожденных подойдет любая, какую только удастся получить. Как собрать мочу на бакпосев у ребенка? У грудничка провести забор мочи можно с помощью специальных полиэтиленовых мочесборников.
Детям постарше нужно предложить помочиться сначала в унитаз, чтобы выпустить первую порцию урины. Затем среднюю часть мочи собрать в стерильный контейнер и в короткие сроки доставить в лабораторию. Для проведения анализа берется около 10 мл урины – этого достаточно для определения имеющихся микроорганизмов.
Правила сбора образца у ребенка предполагают прекращение приема антибиотиков. Поэтому родители должны вовремя предупредить об этом врача, который впоследствии будет расшифровывать результаты.
Методика исследования
Для выделения чистых культур возбудителей на первом этапе прибегают к их посеву на соответствующие среды, который проводится в специальных (стерильных!) условиях. В основном, перенос материала на среду осуществляется с помощью приспособлений, применяемых еще в 19 века великим Луи Пастером:
- Бактериальной петлей;
- Пастеровской пипеткой;
- Стеклянной палочкой.
Конечно, многие инструменты за 2 столетия претерпели изменения, на смену пришли пластиковые стерильные и одноразовые, однако и старые не остались в прошлом, продолжая и поныне служить микробиологической науке.
Первый этап получения колоний требует соблюдения определенных правил:
- Посев осуществляется над спиртовкой в боксе, предварительно обработанном дезинфектантами и кварцеванием, или в ламинарном шкафу, обеспечивающем стерильность в рабочей зоне;
- Одежда медработника, перчатки и среда также должны быть стерильными, поскольку обратное мешает выделению изолированных штаммов;
- Работать в боксе нужно быстро, но аккуратно, нельзя разговаривать и отвлекаться, при этом – необходимо помнить о личной безопасности, ведь материал может быть заразным.
Выделение штаммов и изучение чистых культур
Выделение штаммов не всегда одинаково, поскольку некоторые биологические среды, находящиеся в человеческом организме требуют индивидуального подхода, например, гемокультуру (кровь) сначала в жидкой среде (соотношение 1 : 10) немного «подращивают», поскольку кровь (неразведенная) может убить микроорганизмы, а затем, через сутки или больше, пересевают на чашки Петри.
Посев мочи, промывных желудочных вод и других жидких материалов тоже имеет свои особенности, где для получения чистой культуры, жидкость сначала следует центрифугировать (условия – асептические!), а уж затем сеять, причем не саму жидкость, а ее осадок.
Культивирование и выращивание колоний осуществляют на чашках Петри или помещают сначала в жидкую среду, разлитую в стерильные флакончики, а затем изолированные колонии еще раз высевают, но уже на скошенный агар и помещают материал на сутки в термостат. Убедившись в чистоте полученной культуры, штаммы переносят на предметное стекло, делают мазок и окрашивают по Граму (чаще всего), Цилю-Нильсену и др. и для дифференцировки изучают морфологию микроба под микроскопом:
- Размер и форму бактериальной клетки;
- Наличие капсул, жгутиков, спор;
- Тинкториальные свойства (отношение микроорганизма к окрашиванию)*.
*Читатель, вероятно, слышал о таком возбудителе, как бледная трепонема? Это – возбудитель сифилиса, а ее название (бледная) поэтому и появилось, что она плохо воспринимает краски и остается слегка розоватой при окрашивании по Романовскому. Микроорганизмы, невоспринимающие анилиновые красители называются грамотрицательными, а воспринимающие – грамположительные. Грамотрицательным бактериям придают розовый или красный цвет при окраске по Граму дополнительные красители (фуксин, сафранин).
Бак посев можно назвать древним анализом, однако его популярность от этого отнюдь не падает, хотя современная бактериология имеет возможности выделения не только штаммов, но и отдельной клетки из него, которая называется клоном. Однако для получения клона необходим специальный прибор – микроманипулятор, который в обычных лабораториях отсутствует, поскольку применяется, в основном, в научно-исследовательских целях (генетические исследования).